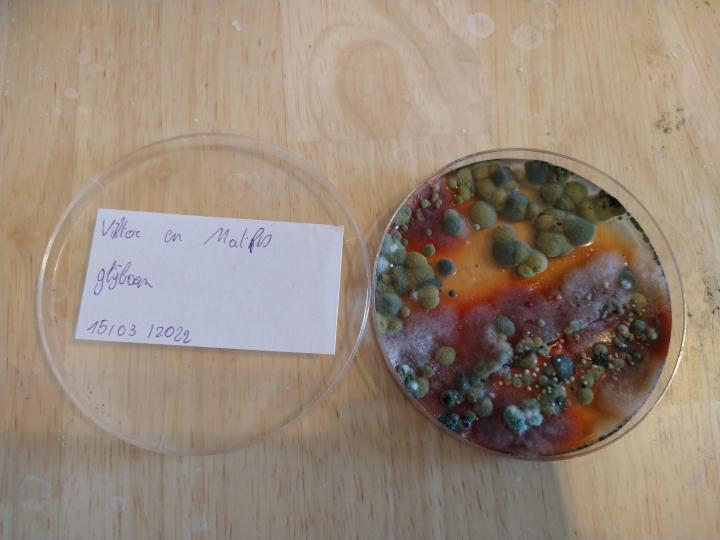

Met een STEM activiteit laat je de leerlingen zelf onderzoeken en aan de slag gaan met een uitdagend probleem.
Achtergrondinformatie
WAT IS STEM?
Zélf een uitdagend probleem oplossen, op onderzoek gaan, creatief denken, ontwerpen en maken: STEM is voor kinderen (en leerkrachten) vaak een andere manier van leren. Het wordt geassocieerd met een verschuiving van het leren van geïsoleerde losstaande feiten en vaardigheden naar het geïntegreerd werken vanuit uitdagende probleemstellingen die meteen gelinkt kunnen worden met de wereld om je heen.
Om die probleemstellingen te kunnen oplossen stappen we in een boeiend proces waarin een voortdurende interactie gebeurt tussen Onderzoeken, Ontwerpen en Optimaliseren.
Een effectieve STEM aanpak steunt hierbij op 4 pijlers
- Betekenisvolle contexten
- Vragen stellen
- Systematisch onderzoek
- Interactie en reflectie
STEM is dus een manier van leren die zowel voor jongeren als volwassenen werkt, omdat er naast domeinspecifieke doelen, vooral ook domeinoverstijgende doelen gestimuleerd worden zoals creativiteit en innovatie, kritisch denken en probleemoplossend vermogen, communicatie en samenwerking.
(Bron: https://vivesweb.be/sterkinstem/)
AAN DE SLAG MET STEM?
Via dit leerpad leer je de basis voor het opmaken van een goede STEM activiteit
Verloop
Stap 1: Ga op zoek naar een betekenisvolle context gelinkt aan je onderwerp. Bedenk hierbij een probleemstelling. Daarbij kunnen er enkele criteria gekoppeld worden aan de probleemstelling. Formuleer de probleemstelling zo dat de leerlingen op verschillende manieren zélf op zoek moeten naar het antwoord. Een STEM activiteit is géén stappenplan volgen.
Bv. Binnenkort komen onze ouders op bezoek. We willen graag een speciaal voorwerp voorstellen aan onze ouders. Daarom hebben we een tekst en een kader nodig
Jullie kader moet aan de volgende criteria voldoen:
- het kader moet minstens 3 hoeken en maximum 6 hoeken hebben
- het kader moet hoofdzakelijk gemaakt zijn uit hout
- het kader moet rechtop kunnen staan
- het kader moet de aandacht trekken
- de tekst in het kader moet duidelijk leesbaar zijn
Stap 2: Selecteer enkele interessante materialen waardoor de leerlingen een oplossing voor het probleem kunnen bedenken. Zorg voor verschillende materialen die de leerlingen op weg helpen. Maak een doordachte keuze, meer materialen is niet altijd beter.
Stap 3: Begeleid de leerlingen. Denk daarbij aan interessante denk- en doe vragen. Zorg dat het proces systematisch gaat (bv. uittesten, dan één variabele aanpassen). Doe de STEM activiteit zelf, zodat je weet waar de leerlingen tegenaan kunnen botsen.
